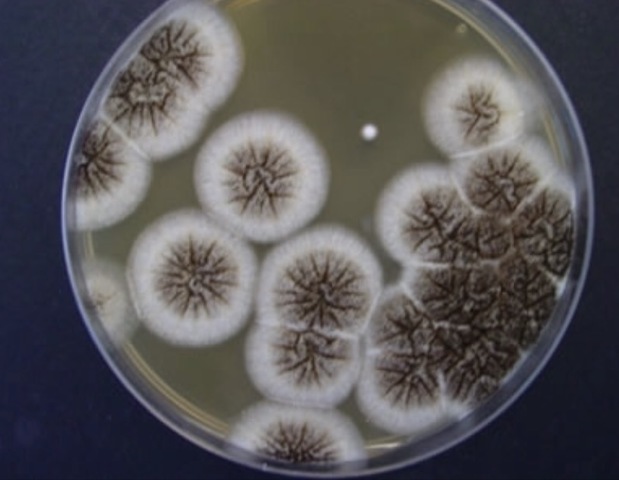
Jokichi Takamine

-
Redacta en La Iliada el uso del estomago de un niño para hacer queso
-
Importancia de las enzimas en la biogénesis
-
Conversión de almidón a glucosa (catálisis)
-
Descubrimiento de la diastasa (1er enzima)
-
Reconoce reacción catalítica por medio de una hidrólisis
-
Interpreta que la fermentación es una reacción catalítica
-
Actividad de la invertasa
-
Fermentación del azúcar a alcohol por "fermentos"
-
Primero en usar el término enzima = modificador
-
Descubre la enzima Takadiastasa, obtenida del Aspergillus oryzae
-
Conversión de glucosa a etanol, por extracto de levadura
-
Aplicación de enzimas pancreáticas con sales biliares en función de la peletería
-
Demostraron la inmovilización de las enzimas
-
Consigue enzima en su forma más pura
-
Aisló enzima ureasa
-
Empezó a producir una proteasa a partir de Bacillus lichnfornis
-
Ingeniería genética
-
Diagnósticos enzimológicos
Want to make a timeline like this?
Use Timetoast to turn dates, events, milestones, and phases into a clear visual timeline you can build and share. Timetoast is a timeline maker for work, school, research, and stories.